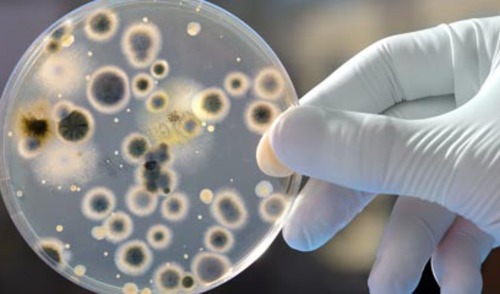

20 godina organiziranog nacionalnog praćenja rezistencije u Hrvatskoj
01.02.2017.
Prvi korak u kontroli širenja antimikrobne rezistencije je poznavanje stopa rezistencije u pojedinih patogena u vlastitoj sredini. Praćenje rezistencije bakterija na antibiotike u humanoj medicini ima u Hrvatskoj dugu tradiciju, usporedivu s praksom u samo malom broju europskih zemalja.
Danas Odbor okuplja voditelje 35 mikrobioloških laboratorija i svojim podacima pokriva više od 90 % hrvatske populacije.
2016. godine obilježena je dvadeseta godišnjica organiziranog nacionalnog praćenja rezistencije u Hrvatskoj koje je započelo 1996. g. osnivanjem Odbora za praćenje rezistencije bakterija na antibiotike u RH pri Kolegiju za javno zdravstvo Akademije medicinskih znanosti Hrvatske (AMZH). Odbor je u početku uključivao rezultate 17 mikrobioloških laboratorija pozvanih da svojim rezultatima predoče situaciju u različitim regijama Hrvatske. Danas Odbor okuplja voditelje 35 mikrobioloških laboratorija i svojim podacima pokriva više od 90 % hrvatske populacije.
Praćenje rezistencije u Hrvatskoj dodatno je unaprijeđeno osnutkom Referentnog centra Ministarstva zdravlja (MZ) za praćenje rezistencije bakterija na antibiotike pri Klinici za infektivne bolesti "Dr. Fran Mihaljević" 2003. g., osnivanjem hrvatske podružnice internacionalne organizacije The Alliance for the Prudent Use of Antibiotics (APUA) i napose osnivanjem Interdisciplinarne sekcije za kontrolu rezistencije na antibiotike (ISKRA), interdisciplinarnog tijela (engl. "intersectorial coordination mechanism", ICM) pri MZ. ISKRA je osnovana 2006. g. i uspješno koordinira različite aktivnosti poput praćenja rezistencije, praćenja potrošnje antibiotika, pisanja nacionalnih smjernica i provođenja javnih kampanja.
Problem rezistencije na antibiotike nadišao je interes struke i postao predmet interesa državničkih tijela, prvenstveno u Europskoj uniji i Sjedinjenim Američkim Državama. I 2016. godine godine, trenutno predsjedavajuća država Europske unije, Nizozemska, sazvala je ministarsku konferenciju posvećenu problemu rezistencije na antibiotike. Poruka ove konferencije je bila da se problemu rezistencije treba pristupiti cjelovito i globalno i u tom smislu se potiče zajedničko djelovanje medicinskog i veterinarskog sektora te suradnja među državama članicama. Od država članica se očekuje da usvoje akcijske planove koji će u nekoliko koordiniranih koraka voditi u ograničavanje rezistencije na antibiotike.
Zahvaljujući postojećoj strukturi Hrvatska se spremno uključuje u razne europske inicijative. Od samih početaka Hrvatska sudjeluje u internacionalnim programima praćenja rezistencije (European Antimicrobial Resistance Surveillance System, EARSS i EARS-Net) i potrošnje (European Surveillance of Antimicrobial Consumption, ESAC i ESAC-Net) antibiotika. Od 2008. g. Europa 18. studenoga obilježava Europski dan svjesnosti o antibioticima (engl. "European Antibiotic Awareness Day", EAAD). Obilježavanju ovog dana priključila se i Hrvatska te od 2008. g. svake godine taj dan obilježava prikladnim simpozijem koji okuplja velik broj liječnika raznih struka i farmaceuta. I u studenom 2015. g. održan je u Zagrebu EAAD Simpozij koji je okupio tristotinjak stručnjaka koji su zajedno raspravljali o raznim aspektima problema rezistencije na antibiotike. U zadnjem broju Infektološkog glasnika predstavljena su odabrana predavanja s tog skupa te radovi hrvatskih stručnjaka koji se uklapaju u temu rezistencije bakterija na antibiotike. Nadamo se da će Vas odabrani članci usmjeriti na što učinkovitiju uporabu antibiotika te potaknuti da i sami sudjelujete u propagiranju racionalne uporabe antibiotika i poticanju javne kampanje za očuvanjem antibiotika u Vašoj sredini.